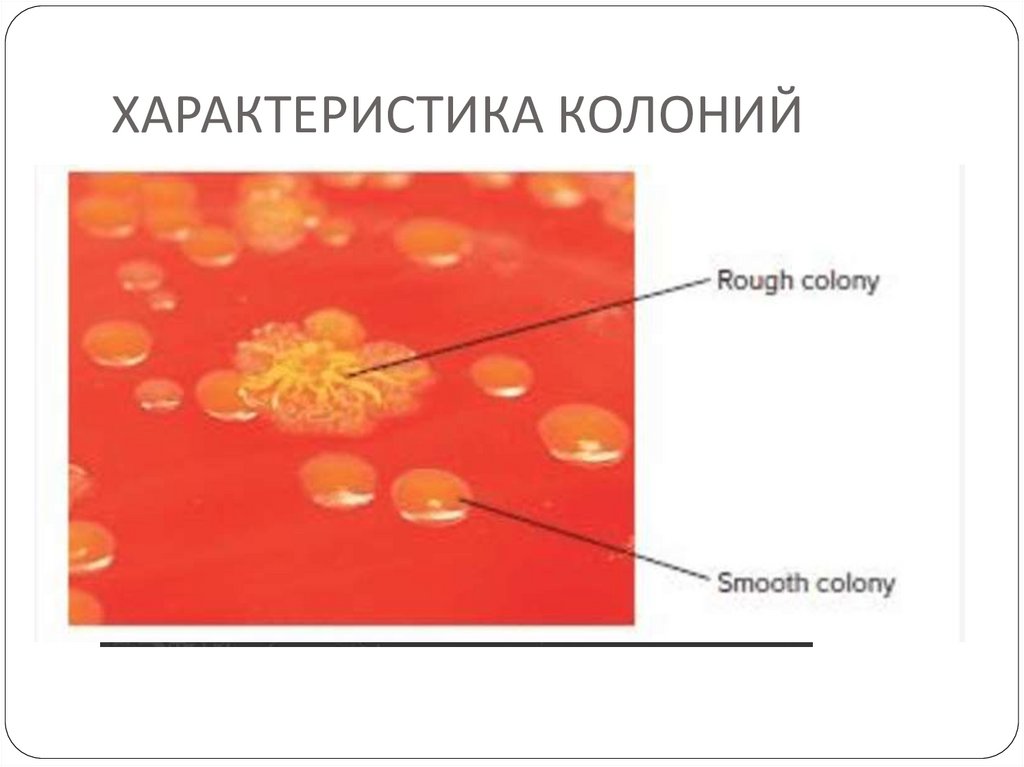

Similar presentations:
Генетика микроорганизмов
1.
ГЕНЕТИКАМИКРООРГАНИЗМОВ.
Наумкина Е.В. д.м.н.,
профессор кафедры
микробиологии и вирусологии с
курсом иммунологии ОмГМУ
2.
Генетический материалбактерий
Бактерии — гаплоидные организмы, т. е.
они имеют 1 хромосому.
В связи с этим при наследовании
признаков отсутствует явление
доминантности, т.е. мутация всегда
передается в следующее поколение
(вертикальная передача генов)
3.
Хромосома бактерий — это молекула ДНК,суперспирализована в петли и свернута в кольцо, которое в
одной точке прикреплено к цитоплазматической мембране.
На бактериальной хромосоме располагаются отдельные
гены.
4.
Функциональными единицами генома бактерий,кроме хромосомных генов, являются:
• IS-последовательности;
• транспозоны;
• плазмиды.
(горизонтальная передача генов)
5.
ПЛАЗМИДЫ - ВНЕХРОМОСОМНЫЕ ГЕНЕТИЧЕСКИЕСТРУКТУРЫ БАКТЕРИЙ.
НЕБОЛЬШИЕ МОЛЕКУЛЫ ДНК,
СПОСОБНЫЕ К АВТОНОМНОЙ РЕПЛИКАЦИИ.
Плазмиды могут быть интегрированы в хромосому (в отличие от ISпоследовательностей и транспозонов, встраиваются в строго определенные
участки), а могут существовать автономно. В этом случае они обладают
способностью к автономной репликации.
ПЛАЗМИДЫ ЛОКАЛИЗУЮТСЯ В ЦИТОПЛАЗМЕ
БАКТЕРИИ
В СВОБОДНОМ ВИДЕ –
ПЛАЗМИДА
В СВЯЗАННОМ С
НУКЛЕОИДОМ ВИДЕ –
ЭПИСОМА
6.
СВОБОДНЫЕ ПЛАЗМИДЫ СПОСОБНЫ КАВТОНОМНОЙ ОТ ХРОМОСОМЫ
РЕПЛИКАЦИИ
ТРАНСМИССИВНЫЕ
ПЛАЗМИДЫ
НЕТРАНСМИССИВНЫЕ
ПЛАЗМИДЫ
САМОСТОЯТЕЛЬНО
ПЕРЕДАЮТСЯ
ДРУГИМ ОСОБЯМ
С ПОМОЩЬЮ
КОНЪЮГАЦИИ
НЕ ИМЕЮТ
АППАРАТА ПЕРЕДАЧИ,
НО МОГУТ
ПЕРЕНОСИТЬСЯ С
ТРАНСМИССИВНЫМИ
ПЛАЗМИДАМИ ИЛИ
ПОСРЕДСТВОМ
ТРАНСДУКЦИИ
7.
РАЗЛИЧАЮТF – плазмиды контролируют синтез половых
пилей
R – плазмиды содержат гены,
детерминирующие синтез ферментов,
разрушающих антибактериальные препараты
Плазмиды патогенности контролируют
вирулентные свойства бактерий
Бактериоциногенные плазмиды
8.
Виды плазмидСol – продукция колицинов
HLy – продукция гемолизинов
Tol – расщепление толлуола,
ксилола
Ent
–
продукция
энтеротоксина
Nif – связывание азота у K.
pneumoniae
Ti – образование опухолей у
растений
Плазмиды деградации:
Саm – расщепление камфоры
Oct - расщепление октана
Sal - расщепление салицина
9.
ФУНКЦИИ ПЛАЗМИДРегуляторная – состоит в компенсации
нарушений метаболизма ДНК клетки хозяина
Кодирующая – состоит во внесении в
бактериальную клетку новой информации, о
которой судят по приобретённому признаку
10.
11.
IS-последовательности — короткиефрагменты ДНК. Они не несут структурных
генов, а содержат только гены,
ответственные за транспозицию
(способность IS-последовательностей
перемещаться по хромосоме и встраиваться
в различные ее участки). Самостоятельно не
реплицируются.
Функции: активация и инактивация генов
12.
Функции IS-элементовКоординирующая: взаимодействие
транспозонов, плазмид, умеренных
фагов между собой и хромосомой
бактерии, обеспечивая их репликацию.
2. Регуляторная: вызывают инактивацию генов, или служат промоторами
(участки ДНК, которые регулируют
экспрессию клеточных генов).
3. Индуцируют мутации по типу
делеции или инверсии
1.
13.
Транспозоны — это молекулы ДНК, болеекрупные, чем IS-последовательности. Помимо
генов, ответственных за транспозицию, они
содержат и структурный ген, кодирующий тот
или иной признак.
Транспозоны легко перемещаются по
хромосоме. Транспозоны могут существовать
вне хромосомы, автономно, но неспособны к
автономной репликации.
Функции: кодируют образование токсинов и
ферментов, разрушающих антибиотики.
14.
Функции транспозонов1. Регуляторная.
2. Кодирующая.
3. Индуцируют мутации.
4. Вызывают хромосомные аберрации.
15.
Фенотипическая и генотипическая изменчивостьГенотип – общая сумма генов, которыми
обладает микробная клетка.
Фенотип – общий комплекс морфологических
признаков и физиологических свойств
микроорганизма, и служит внешним
проявлением генотипа.
16.
Наследственность – способность живых организмовсохранять определенные признаки на протяжении
многих поколений.
Изменчивость – приобретение новых признаков,
отличающих их от других поколений под влиянием
факторов внешней среды.
17.
У бактерий различают 2 вида изменчивости —фенотипическую и генотипическую.
Фенотипическая изменчивость — не затрагивает
генотип. Модификации не передаются по
наследству и с течением времени затухают, т. е.
возвращаются к исходному фенотипу через
большее (длительные модификации) или меньшее
(кратковременные модификации) число поколений.
Генотипическая изменчивость затрагивает
генотип. В ее основе лежат мутации и
рекомбинации.
18.
МОДИФИКАЦИИФенотипические изменения какого-либо
признака или нескольких признаков
микроорганизма
Не сопровождаются изменениями первичной
структуры ДНК и вскоре утрачиваются
19.
ПРИМЕРЫ МОДИФИКАЦИЙL-трансформация
Включение «молчащих» генов некоторых
микроорганизмов, в результате чего
происходит смена их Аг в ходе инфекционного
заболевания (напр., боррелии – возбудители
возвратных тифов)
Стафилококки только в присутствии
пенициллина синтезируют фермент,
разрушающий данный антибиотик
20.
ДИССОЦИАЦИЯВозникает вследствие образования 2-х форм
бактериальных клеток, которые отличаются
друг от друга по характеру образуемых ими
колоний на твёрдой питательной среде
21.
ХАРАКТЕРИСТИКА КОЛОНИЙS - колонии (англ. smooth – гладкий) круглые,
влажные, с блестящей гладкой поверхностью и
ровными краями
R – колонии (англ. rough - неровный, грубый) –
неправильной формы, непрозрачные, сухие, с
неровными краями и шероховатой
поверхностью
22.
Свойства микробов S-колонийКлетки нормальной морфологии
Диффузное помутнение бульона
У подвижных видов есть жгутики
У капсульных вариантов есть капсулы
Биохимически более активны
Полноценны в антигенном отношении
У патогенных видов – вирулентны
Выделяют в остром периоде заболевания
Чувствительны к бактериофагам
Менее чувствительны к фагоцитозу
23.
Генотипическая изменчивость1. Мутации
Возникновение
под действием
физических
химических и
биологических
мутагенов
2. Рекомбинации:
Конъюгация
Трансдукция
Трансформация
24.
Мутации:Вертикальная передача генов
Рекомбинации:
Горизонтальная передача генов
Вертикальная передача генов – от «родителя» к потомству.
Горизонтальная передача генов происходит между двумя
различными микроорганизмами.
25.
МутацииГоризонтальная
передача генов
Разнообразие бактериального генома
Эволюция
26.
Мутации бактерийПо происхождению мутаиии могут быть:
• спонтанными – причина возникновения неизвестна;
• индуцированными – направленное действие физических,
химических, биологических факторов.
Спонтанные мутации возникают самопроизвольно
Индуцированные мутации происходят с гораздо большей
частотой , возникают в результате воздействия мутагенов:
- физических – УФ-лучи, γ-радиация
- химических – аналоги пуриновых и пиримидиновых
оснований
- биологических - транспозоны
27.
Действие мутагеновна бактерии
Различные физические и химические факторы повышают частоту мутаций.
Ультрафиолетовое излучение и диоксин являются мутагенами и вызывают
образование мутантов (коасные клетки)
28.
По протяженности:• точечными - изменение одного или
нескольких нуклеотидов ДНК;
делеция
инсерция (вставка)
замена:
транзиция (пуриновая основа – на пуриновую,
пиримидиновая – на пиримидиновую)
трансверзия (пуриновая основа – на пиримидиновую и
наоборот)
29.
• генными – изменение гена;• хромосомными – перестройки целых фрагментов
ДНК.
делеции – выпадение пар
нуклеотидов
дупликации – добавление
нуклеотидов
транслокации – перемещение
нуклеотидов
инверсии – перестановка
нуклеотидных пар
30.
Мутации бактерийПо направленности:
- прямыми – появление мутантного генотипа, возврата к
нормальному генотипу не происходит;
-обратными (реверсии) – происходят в мутантном генотипе и
вызывают его возврат к нормальному .
По локализации:
нуклеоидные
цитоплазматические
31.
Рекомбинации (обмен генетическимматериалом) у бактерий
32.
1. Конъюгация2. Трансдукция
3. Трансформация
33.
КонъюгацияКонъюгация — обмен генетической информацией у бактерий путем
передачи ее от донора к реципиенту при их прямом контакте. После
образования между донором и реципиентом конъюгационного
мостика одна нить ДНК клетки-донора поступает по нему в
клетку-реципиент. Донорской функцией обладают F+-клетки
(содержащие плазмиду фертильности).
34.
Эксперимент Ледерберга и Татума, демонстрирующийрекомбинацию у Е.coli (1946)
Штамм А
Штамм B
треонин лейцин -
биотин метионин тиамин Смесь A и B
Минимальная среда без аминокислот: thr, leu, bio, met и thi
Отсутствие
роста
Отсутствие
роста
Прототрофные колонии
Рекомбинация между двумя комплементарными ауксотрофными мутантами
приводит к тому, что они становятся способными синтезировать все
необходимые аминокислоты
35.
1.2.
3.
Необходим прямой контакт между клетками.
При конъюгации возможна передача большого количества генетического
материала.
Донорную способность определяют плазмиды фертильности, благодаря
которым бактерии образуют половые пили, обеспечивающие контакт
клеток друг с другом (цитоплазматический мостик).
Реципиент генов
= «женская» клетка
Отсутствие плазмиды F
Донор генов
= «мужская клетка»
Наличие плазмиды F
36.
ТрансдукцияПеренос фрагмента ДНК одной бактерии в другую с помощью
бактериофага
37.
Трансдукциянеспецифическая
Переносятся любые гены,
захваченные
бактериофагом
специфическая
Переносятся определенные гены. Вблизи от
них встраивается и умеренный бактерофаг
Лизогенная конверсия
Вследствие интеграции генов умеренного
бактериофага в хромосому бактерии,
изменяется ее генотип и бактерия
приобретает новые свойства
38.
ТРАНСДУКЦИЯ39.
40.
ТрансформацияЭто передача генетической информацией путем
введения фрагмента свободной растворимой ДНК,
выделенной из клетки-донора в бактериальную клеткуреципиент.
Чаще всего передача генетической информации происходит
при культивировании реципиента на питательной среде,
содержащей ДНК донора.
При трансформации передаются единичные признаки.
Трансформация является самым объективным
свидетельством связи ДНК или ее фрагментов с тем или
иным фенотипическим признаком, поскольку в
реципиентную клетку вводится чистый препарат ДНК.
41.
Условия, необходимые для трансформацииТрансформация зависит от :
- самих бактерий и их способности быть реципиентами: понятие
компетентности
Компетентность – это способность клеток поглощать ДНК
бактерии-донора и включать ее в состав своей хромосомы
- Вводимой ДНК и ее свойств
Трансформирующая ДНК и ДНК бактерии-реципиента должны
быть схожи. Трансформация возможна только между бактериями
одного вида и родственных видов.
42.
ДНК может проникать только в компетентные клеткиПриродная
компетентность
Искусственная
компетентность
43.
Природная компетентностьПриродная компетентность
бактериальных клеток
Bacillus subtilis,
Streptococcus spp,
Haemophilus influenzae,
Neisseria spp
Эти бактерии способны воспринимать свободную ДНК из внешней среды.
В природе трансформация происходит спонтанно и очень редко
44.
Искусственная компетентностьТермический шок
Хлорид кальция
электропорация
Некомпетентные изначально бактерии
Бактерии приобрели компетентность
во время
экспоненциальн
ой фазы
роста
45.
Трансформация (опыты Гриффитса, 1928; Евери МкЛеода и Макарти, 1944)
46.
ТРАНСФОРМАЦИЯ47.
КонъюгацияТрансдукция
Трансформация
рекомбинациии
48.
Трансдукция – передача генетическогоматериала от донора реципиенту при помощи
бактериофага .
Трансформация – передача генетического
материала от донора реципиенту при помощи
изолированной ДНК.
Конъюгация - это передача генетического
материала от бактерии-донора к бактерииреципиенту путем непосредственного контакта.
49.
Молекулярнаябиология
Микробиология
Генетика
Биохимия
Химическая
инженерия
Клеточная
биология
Молекулярная
биотехнология
Высокоурожайные
культуры
Лекарственные препараты
Вакцины
Диагностические
методы
Высокопродуктивные сельскохозяйственные
животные
50.
История развития молекулярнойбиотехнологии
Год
1917
1944
Событие
Карл Ереки ввёл термін “биотехнология”
1953
Уотсон и Крик расшифровали структуру ДНК
1970
1973
Виделена пераая рестриктирующая эндонуклеаза
1978
1982
1988
Получено первый человеческий инсулин
Евери, МакЛеод, МакКарти доказали, что генетическим
материалом является ДНК
Бойєр, Коэн заложили основу технологии
рекомбинантных ДНК (гибрид фага λ м E. coli)
Первая вакцина для животных
Открыто метод ПЦР
51.
История развития молекулярнойбиотехнологии
Год
1990
1996
1996
1997
Событие
Начало работы над проектом “Геном человека”
Продажа первого рекомбинантного белка
эритропоэтина перевысила 1 млрд долларов
США
Определено генетическую последовательность
всех хромосом эукариотического организма
Saccharomyces srevisiae
Клонирование млекопитающего из соматической
клетки
52.
F. Crick i J. WatsonWatson J.D., Crick F.H.C. Molecular structure of nucleic acids // Nature. 1953. V. 171. P. 738-740
"А мы только что
открыли секрет жизни!"
53.
В шестидесятых годах прошлого века былопоказано, что в процессе репликации ДНК
принимает участие специальный белок –
ДНК-полимераза.
В семидесятых годах появились еще два
важнейших метода - секвенирование и
получение рекомбинатной ДНК.
Секвенирование позволяет "прочитать"
последовательность нуклеотидов в ДНК.
Именно на этом методе основана вся
программа "Геном человека".
Получение рекомбинантной ДНК молекулярное клонирование.
В молекулу ДНК встраивают фрагмент,
содержащий определенный ген. Таким
образом получают бактерии, которые
содержат ген человеческого инсулина
(рекомбинантный инсулин).
Этим же методом созданы все "генетически
модифицированные продукты".
54.
ПРОДУЦЕНТЫ, которыечаще всего используются
в биотехнологии
ЭУКАРИОТЫ – дрожжи, плесневые грибы,
культуры клеток животных, людей и растений
ПРОКАРИОТЫ – кишечная палочка, аэробные
бациллы, псевдомонады, актиномицеты.
55.
СФЕРЫ ИСПОЛЬЗОВАНИЯБИОТЕХНОЛОГИИ
56.
Основные продукты, которые получают припомощи биотехнологии
В медицине
В ветеринарии
та с/х
В пищевой
промышлености
В химической
промышлености и
энергетике
Антибиотики
Витамины
Аминокислоты
Гормоны
Вакцины
Компоненты крови
Диагностические
препараты
Нуклеиновые
кислоты
Противоопухолев
ые агенты.
Кормовий белок
Пищевые
антибиотики
Витамины
Гормоны
Вакцины
Биологические
средства защиты
растений
Инсектициды
Амінокислоти
Пищевой белок
Ферменты
Ацетон
Этилен
Бутанол
Биогаз
Спирты
57.
Некоторые гормоны человека, продуцируемыерекомбинантными микроорганизмами
Белок
Название препарата
Инсулин
Гумулин, Новолин
Соматостатин
Протропин, Гуматроп
Интерферон-альфа
Роферон, Велферон
Интерферон-гамма
Актимун
Интерферон-бета
Фрон, Бетасерон
Интерлейкин-2
Пролейкин
Фактор некроза опухолей
-
Эритропоэтин
Прокрит, Эпоген
Гранулоцит колониестимулюющий фактор
Филграстин, Ньюпоген
Плазминоген активатор
Актилиз
58.
Генная инженерия –направленное изменение генома продуцента в
нужном для человека направлении:
пересадка в геном продуцента генов других
организмов (человека, животного, растения),
кодирующих синтез необходимого человеку
продукта.
59.
“ИНСТРУМЕНТЫ"ДЛЯ ГЕННОЙ ИНЖЕНЕРИИ
ФЕРМЕНТЫ (рестриктазы, лигазы, обратная
транскриптаза)
ВЕКТОРЫ
(плазмиды, умеренные
бактериофаги, космиды, транспозоны, вирусы)
60.
ЗНАЧЕНИЕ ПЛАЗМИД В ГЕНЕТИЧЕСКОЙИНЖЕНЕРИИ
Генетическая инженерия сводится к
генетическим рекомбинациям
Метод рекомбинации in vitro заключается:
1 – в выделении или синтезе ДНК из
отличающихся друг от друга организмов или
клеток
2 – получении гибридных молекул ДНК
3 – введении рекомбинантных (гибридных)
молекул в живые клетки
4 – в создании условий для экспрессии и
секреции продуктов, кодируемых генами
61.
Гены, кодирующие те или иные структурывыделяют с помощью ферментов рестрикции
Полученный целевой ген с помощью ферментов
лигаз сшивают с другим геном, который
используется в качестве вектора (векторы плазмиды, бактериофаги)
Экспрессируемый ген в виде рекомбинантной
ДНК встраивается в клетку, которая
приобретает новое свойство – продуцировать
несвойственное этой клетке вещество,
кодируемое экспрессируемым геном
62.
В качестве реципиентов чаще всего используютEscherichia coli, дрожжи, вирусы
В медицине применяют полученные методом
генетической инженерии вакцины
против гепатита В; интерлейкины-1,-2,-3;
инсулин; гормоны роста; интерфероны α,
β, γ; фактор свёртываемости крови; многие
антигены для диагностических целей

biology
biology








